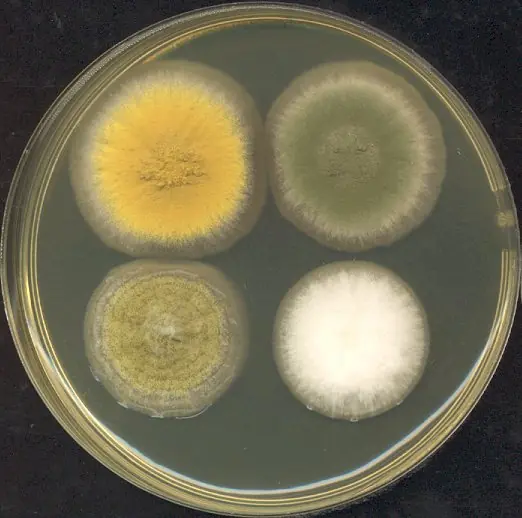
Cook Snap von kochcode-team

Hausgemachter Kōji-Reis (Grundrezept)
Die Seele der japanischen Fermentationskunst. Dieser mit dem Edelschimmel Aspergillus oryzae veredelte Reis bildet das aromatische Fundament für Miso, Sake, Sojasauce und Shio Kōji. Ein Prozess, der Geduld erfordert und mit tiefem Umami belohnt wird.
Wann möchtest du das kochen?
Zutaten
-
500 g🥄Rundkornreisvorzugsweise Sushireis
-
2 g🥄Kōji-kinAspergillus oryzae Sporen in Pulverform
-
 Wasserzum Einweichen und Dämpfen
Wasserzum Einweichen und Dämpfen
🧮 Nährwerte pro Portion
Noch nicht genug Zutatendaten verknüpft (67%). Ab 70 % werden hier automatisch Nährwerte pro Portion angezeigt.
Vollständige Analyse🧻 Verbrauchsmaterial
Hast du alles?
Klicke auf ein Werkzeug für Kaufempfehlungen
💡 Wusstest du schon?
Kōji ist der Eckpfeiler der japanischen Fermentationskunst und wurde bereits im 8. Jahrhundert n. Chr. urkundlich erwähnt. Ursprünglich mit wilden Sporen gewonnen, revolutionierte die Reinzucht der Schimmelkulturen in der Meiji-Ära die Herstellung von Umami-Spendern wie Miso und Sojasauce. Heute gilt der Aspergillus oryzae als 'Nationalpilz' Japans und verleiht Speisen eine einzigartige, natürliche Süße und komplexe Tiefe.
Zubereitung
Reis vorbereiten
-
1
Waschen
Wasche den Reis gründlich unter fließendem Wasser, bis dieses vollkommen klar bleibt. Dies entfernt überschüssige Stärke, die den Reis später zu klebrig machen würde.
-
2
Einweichen
Weiche den Reis für ca. 6 bis 12 Stunden in reichlich kaltem Wasser ein. Die Körner sollten sich danach leicht zwischen den Fingern zerdrücken lassen.
- 💡 Bei warmen Temperaturen reicht eine kürzere Einweichzeit, im Winter darf es etwas länger sein.
Dämpfen & Abkühlen
-
1
Dämpfprozess
Lasse den Reis gut abtropfen. Kleide den Dämpfaufsatz mit einem feuchten Tuch aus und dämpfe den Reis für ca. 40-50 Minuten. Der Reis sollte 'al dente' sein – innen gar, aber außen fest und nicht klebrig.
-
2
Abkühlen
Breite den gedämpften Reis in einer Holzschale aus. Lasse ihn unter gelegentlichem Wenden auf exakt 35-40 °C abkühlen.
- 💡 Nutze unbedingt ein Thermometer. Ist der Reis zu heiß, sterben die Sporen ab; ist er zu kalt, wächst der Pilz zu langsam.
Beimpfen & Fermentation
-
1
Sporen verteilen
Siebe das Kōji-kin Pulver gleichmäßig über den Reis. Vermenge alles gründlich mit sauberen Händen, damit jedes Reiskorn mit den Sporen in Kontakt kommt.
-
2
Erste Inkubationsphase
Wickle den Reis fest in das Tuch ein und lege ihn in den Gärschrank. Halte die Temperatur konstant bei ca. 30-32 °C für die ersten 24 Stunden.
-
3
Aufbrechen & Belüften
Nach 24 Stunden haben sich kleine weiße Punkte gebildet. Brich die Klumpen vorsichtig auf, um Sauerstoff zuzuführen und die Wärme gleichmäßig zu verteilen.
-
4
Abschluss der Reifung
Lasse den Reis für weitere 12-24 Stunden fermentieren. Der Kōji ist fertig, wenn der Reis vollständig von einem weißen, samtigen Myzel umschlossen ist und angenehm nach Marzipan oder Pilzen duftet.
📸 Cook Snaps 4

@kochcode-team
Shoyukoji – Foto: ウェルワィ at Japanese Wikipedia (CC BY-SA 3.0)
@kochcode-team
Four 3-day old Aspergillus colonies on a Petri dish – Foto: Adrian J. Hunter (CC BY-SA 3.0)

@kochcode-team
Aspergillus tubingensis FJBJ11 – Foto: Qing-Wei Tan, Fang-Luan Gao, F (CC BY 4.0)

@kochcode-team
Aspergillus niger meaox – Foto: Line Ledsgaard Jensen, Mikael (PUBLIC DOMAIN)
📸 @
/
Deinen Cook Snap teilen
Bildeditor wird geladen...
Original: MB → Komprimiert: KB ✓
Bildausschnitt wählen
Feedback (0)
Du musst angemeldet sein, um Feedback zu geben.
Jetzt EinloggenNoch kein Feedback vorhanden. Sei der Erste!
Diskussion
Fragen stellen, Tipps teilen oder Varianten vorschlagen
❓ Fragen & Antworten
Du musst angemeldet sein, um eine Frage zu stellen.
Jetzt EinloggenNoch keine beantworteten Fragen. Stelle die erste!
· Zutatendatenbank-Verknüpfung
📷 Bild-Zuordnung ändern
Keine Ergebnisse gefunden
⚖️
↑ Bitte Gewicht eingeben, um bestätigen zu können
Alternativen:
Keine Ergebnisse
🔢 Nährwert-Zuordnung ändern
⚖️
Keine Ergebnisse gefunden
✅ Zuordnung gespeichert!
